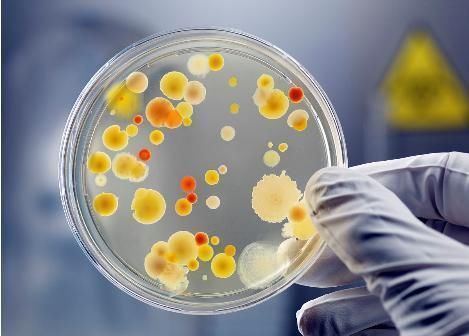
火狐电竞官方网站

来源:火狐(电竞中国)官方网站 发布时间:2025-12-04 01:30:02 点击量:
全球品牌畜牧网讯: 日前,广东惠州首现一例人病毒感染H7N9禽流感疑似病例,患者专门从事活禽屠宰工作,目前病情更为危重。目前排查范围已不断扩大到70多人,都并未检测有H7N9病毒,也未见有出现异常反应。 8月6日,惠州市疾控中心在常规监测过程中,找到惠州市中心医院检验的一例流感样病例样本H7N9初筛阳性,经广东省疾控中心实验审核阳性,融合该病例活禽曝露史初步判断为人病毒感染H7N9禽流感疑似病例。
女患者专门从事活禽屠宰工作 据报,患者陈某某,女,51岁,系由惠州市博罗县斜河镇墟镇河东路人,在博罗墟镇市场专门从事家禽屠宰工作多年。她的档口和家庭二合一,楼上住人、楼下专门从事家禽屠宰。陈某某和老公、儿子同寄居,女儿为一名护士,平时很少回家。
患者目前经常出现呼吸衰竭等问题,病情更为危重,惠州于是以的组织力量全力医治。现场专家透漏,有可能并转送往广州化疗。 陈某某所在的家禽档口坐落于离县城60多公里的小镇,小镇只有一个规模较小的农贸市场,有8个家禽档。

事发后当地已对市场上家禽档口展开重开,捕杀了78只禽鸟。对于涉案禽鸟,农业部门正在本源查出。 惠州市疾控中心无意36名密切接触者实行医学观察,目前并未发现异常。正在惠州的组织防控的广东省疾控中心首席专家、传染病防治掌控所所长何剑峰透漏,目前排查范围已不断扩大到70多人,都并未检测有H7N9病毒,也未见有出现异常反应。
事发现场 患者家人平时都在档口睡觉 羊城晚报讯 9日下午,记者回到疑似病例再次发生的惠州市博罗县斜河镇,据横河镇的谭女士讲解,病患姓氏陈,是其同学的母亲,5日经常出现痉挛症状,当时以为是普通发烧,6日发烧不弃,送到医院检查。谭女士说道:他们一家四口人,母亲现在在医院救治,儿子、女儿、老公都被隔绝。 我们也是今天上午才告诉是禽流感的,谭女士说道,今天小镇来了很多人,有卫生局的、检验检疫局的,就连消防车也回到了现场,对现场展开洗手和消杀。
我家的两只鸡没追查问题,因为饲在二楼,常常清理。 据报,陈姓病患家就在博罗斜河镇菜市场买活鸡。记者在现场看见,菜市场正在集中于消毒,患者家档口是一栋二层楼房,现被查禁,档口的鸡已被集中于运出封存。记者找到,现场的卫生状况较好,家禽屠宰就在档口已完成。
据患者一家人讲解,平时患者家人睡觉都在档口。 大规模人传人可能性并不大 对于接下来的防控,何剑峰说道,广东早就转入常态化,所以疑似病例再次发生后防控措施未有过于大转变。该病例与之前对H7N9的了解也基本相同,主要是反击中老年人,且染病后发作较急。

从病毒毒性上看,虽然比H5N1更容易病毒感染人,但总体的传播和病毒感染方式基本相同。何剑峰建议,市民日常生活中对禽鸟的烹饪要煮熟,而且生熟分离;如果有发烧感冒症状多达一周要及时就诊,并向医生告诉禽鸟认识情况;平时强化体育锻炼,强化肌体免疫力。 何剑峰说道,日前也有国外杂志发表文章证明H7N9禽流感病毒不存在一定人传人风险,但从病毒研究上看,并没有夺权之前的了解,病毒也仍是禽源性,没可病毒感染人的基因受体,大规模人传人可能性并不大。 天气虽热足以杀掉病毒 一般来说,病毒害怕高温,多在炎热季节风行,到夏天就消失了。
最近中国有如一个大烤箱,多地温度飙到40℃,广东也持续高温,为何没想到在这时广东经常出现了人病毒感染禽流感病例? 回应何剑峰说道,一般来说,气温低显然有利于病毒的存活和传播,但自然界的高温尚能足以杀掉病毒,所以夏天的病毒还是有一定的传播能力。之前经常出现较多的H5N1病毒就是这种情况,一年四季都可病毒感染。何剑峰说道。
本文关键词:火狐电竞,火狐电竞官方网站,火狐电竞官网
本文来源:火狐电竞-www.1905mall.com







